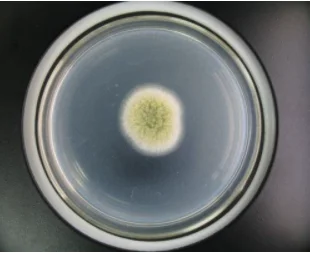
Аспергилл орyzae

Аспергилл орyzae
- Category: Microecology >>>
- Supplier: Hebei Green Element Biotechnology Co. Ltd.
Share on (1600446826643):
Product Overview
Description
Product Description


Specification
item | Aspergillus oryzae |
Type | Soybean paste |
Product name | Aspergillus oryzae |
Function1 | brewed soy sauce |
Function 2 | Soybean paste |
Function 3 | straw decomposing agent |
Storage | Cool Dried Storage |
Odor | Slight Fermentation Odor |
Delivery time | Within 10 Working Days |
SAMPLE | Avaliable |
Product Catalogue

Packing & Delivery


10L/20L/50L/1000L
Company Profile



The company is located in Hebei with convenient transportation, the departure station of the China-Europe freight train, and 300 kilometers away from Tianjin Port. The company focuses on the export trade of bio-organic fertilizer, compound fertilizer, a large number of element water-soluble fertilizers, and the research and development and customization of small batch products to meet the needs of different customers.
FAQ
1. who are we?
We have been engaged in this industry for 15 years and have accumulated rich experience, specializing in the production of bio-organic fertilizers, compound fertilizers, and starting to develop export business in 2021.
2. how can we guarantee quality?
After the order is placed, the order will be sent to the production and technical departments for double review. From the
beginning of the feeding process, the merchandiser is responsible for supervising each step and doing product sampling. The last link QC is responsible for supervising the loading of the container and recording the actual gross net weight
3.what can you buy from us?
Microbial agents,Biological Products,Enzyme,Plant fertilizer,Feed additives
4. why should you buy from us not from other suppliers?
1.Professional technical experts, providing pre-sale and after-sale technical guidance
2.Sales manager with 20 years of experience in import and export business to provide thoughtful service
3.Best quality in its class No low quality products for sale
5. what services can we provide?
Accepted Delivery Terms: FOB,CIF,Express Delivery,DAF;
Accepted Payment Currency:USD;
Accepted Payment Type: T/T,MoneyGram,Credit Card,Western Union,Cash;
Language Spoken:English,Chinese
We have been engaged in this industry for 15 years and have accumulated rich experience, specializing in the production of bio-organic fertilizers, compound fertilizers, and starting to develop export business in 2021.
2. how can we guarantee quality?
After the order is placed, the order will be sent to the production and technical departments for double review. From the
beginning of the feeding process, the merchandiser is responsible for supervising each step and doing product sampling. The last link QC is responsible for supervising the loading of the container and recording the actual gross net weight
3.what can you buy from us?
Microbial agents,Biological Products,Enzyme,Plant fertilizer,Feed additives
4. why should you buy from us not from other suppliers?
1.Professional technical experts, providing pre-sale and after-sale technical guidance
2.Sales manager with 20 years of experience in import and export business to provide thoughtful service
3.Best quality in its class No low quality products for sale
5. what services can we provide?
Accepted Delivery Terms: FOB,CIF,Express Delivery,DAF;
Accepted Payment Currency:USD;
Accepted Payment Type: T/T,MoneyGram,Credit Card,Western Union,Cash;
Language Spoken:English,Chinese
We Recommend
New Arrivals
New products from manufacturers at wholesale prices